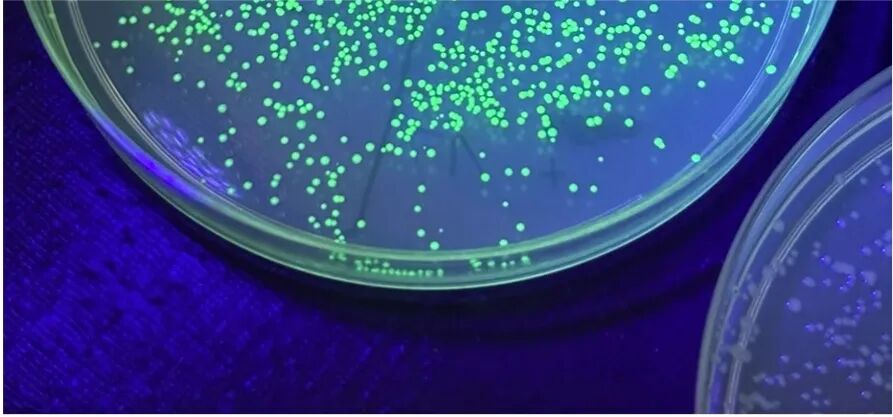
名校科研：26暑XLAB德国哥廷根大学科研：生物/化学/物理方向进！

德国哥廷根大学国际科研项目
信息速递:2026年暑假,XLAB德国科研项目继续面向全国范围内优秀理工科高中生开放报名!两大课题方向可选,仅36个名额!
时间: 2026年07月19日-07月29日
01.
德国哥廷根大学
诺贝尔奖的摇篮:
诞生了45位诺贝尔奖获得者
哥廷根大学(University of Göttingen)是德国一所世界顶尖的综合性大学,也是欧洲常春藤联盟科英布拉集团的重要成员,被誉为诺贝尔奖的摇篮。哥廷根大学名人辈出,从1737年建校至今,共有45位诺贝尔奖获得者,位列德国第一。近现代的科学巨匠高斯、普朗克、海森堡、奥本海默、费米、玻尔、泡利等曾在此读书或任教。其拥有的欧洲神经科学研究、分子生物学研究、大脑分子生理学研究、环境科学研究等科学中心科研实力全球领先,是全球无可争辩的科学中心。
02.
哥廷根大学XLAB
欧洲最受欢迎的高中生科研项目之一
XLAB国际科研项目是哥廷根大学为全球优秀青年提供的实验室科研项目,涵盖生物学、 化学、 物理学等学科的前沿课题。所有课程均由哥廷根大学的科学家及其所在的专业研究机构精心设计,在世界一流的理科实验室里完成授课与科学研究。
该项目旨在通过理论教学与科学实验之间的互动,培养同学对科学的兴趣与探索精神,鼓励他们寻找有效的科研方法。同学们将在哥廷根大学优秀科学家指导下充分体验具有挑战性的科学实验和理论探索,进行不同于常规课堂教学的思维锻炼和实验室科研技能训练。
点击边框调出视频工具条
XLAB
03.
为什么选择
权威 | 稀缺 | 专业 | 前沿 | 实验 | 证书

权
威
世界级科研平台
20年历史,德国前联邦总统和诺贝尔奖获得者强烈推荐,培养优秀未来世界级科学家的平台
稀
缺
每年全球仅录取500人
每年超过50个国家数千名优秀理科生申请其暑期科研项目
专
业
汇集专家级教授
一流科学家亲自设计实验和教学,在世界顶级实验室带领同学做科研
前
沿
三大学科前沿课题
深度体验物理学、化学、生物学三大学科前沿课题
实
验
科研在于实验
在实验中学习理论颠覆传统课堂教学模式,全面训练科学思维和研究能力
证
书
双证书助力背景提升
德国哥廷根大学XLAB项目官方结业证书与UCAS官方推荐的“ASDAN Science Award”证书
04.
课题方向
寒假课题分为两大方向:
A班聚焦生物学:涵盖分子生物学,神经生物学,遗传学,免疫学等方向
B班聚焦物理及化学:涵盖有机化学,无机化学,医学化学等方向
生物学方向
从基因到蛋白质
从基因到蛋白质,是分子生物学领域的经典实验。它完整复现了生命科学自上世纪70年代以来最核心的研究范式:利用质粒作为“基因货车”,通过热激转化将其送入细菌“工厂”,最终让绿色荧光蛋白(GFP)成功表达并发光,也是诺奖技术得以诞生的基础工具组合。
光传导
光传导实验课程是一次跨入神经生物学前沿的实践,它带领学生从分子机制到整体功能,完整地探究“视觉”这一生命奥秘。通过这个实验,学生将亲身验证课本中的光转导信号通路,理解从单个光子被感光细胞中的视紫红质捕获,到最终引发神经电信号的完整过程。是对生命如何感知世界、处理信息的根本性探索,培养学生用定量和实证的方法研究复杂生命现象的能力。
微塑料

微塑料实验课程是一次紧贴全球环境议题的跨学科探究,它巧妙地将化学合成、材料科学与环境生物学融为一体。学生亲手合成两种经典的塑料——聚乳酸和聚苯乙烯,理解其从单体到材料的转变。随后,亲眼见证并制造出微米级的合成纤维,直观理解微塑料的一种来源。体现了现代生物学的跨学科前沿性,完整地探究了微塑料这一“人造物质”对生命世界的潜在影响,培养了学生解决复杂真实环境问题的综合科学素养。
生物膜

生物膜实验课程是一次深入生命基本单位的探索,引导学生亲手构建并研究“细胞膜”这一生命的关键结构。将课本上抽象的细胞膜图示变成了学生手中可创造、可观测、可操控的真实研究对象,让学生从分子相互作用的层面,深刻理解生命如何通过一道精密的“膜”来维持内环境、进行物质交换和信号传递,是连接化学、物理与生命科学的典范性实践。
化学物理方向
阿司匹林的合成与分析
阿司匹林的合成与分析实验是一次从历史药方到现代药学的完整旅程,它带领学生亲手复现和剖析了一粒经典药物的诞生。不仅仅是一次化学合成,更是一次完整的“药物研发”微型实践,它深刻揭示了化学如何通过分子结构的微小改变(乙酰化)来优化药物性能,并训练学生从制备、鉴定到定量分析的全链条科研逻辑,是连接基础有机化学与药学、医学应用的典范。
茶与咖啡因

茶与咖啡因实验课程引导学生运用一套完整的天然产物研究方法,亲手揭开一杯茶背后的化学奥秘。整个过程中,学生将亲身体验如何将一种复杂的天然混合物(茶叶)逐步分离、提纯并鉴定其中的特定活性成分。掌握“分离、鉴定、分析”这一核心科研逻辑,完美体现了化学如何连接日常生活、植物学与药物科学,培养学生严谨的实证思维和对天然产物的科学认知。
聚合物合成与性质

本实验课程是一次从森林到实验室的绿色材料探索之旅,学生亲手将植物原料转化为各种高性能的塑料材料,亲身实践可持续发展的化学理念。让学生通过一系列完整的合成与改性实验,深刻理解如何利用可再生资源设计和制造环境友好型材料,连接传统有机化学、高分子科学与前沿绿色科技,极大地培养学生的循环经济思维和解决实际环境问题的创新能力。
波动物理

波动是物理学中物质运动的常见形式。波动物理实验是一个将无形的波动化为有形数据的经典物理探究。这个实验的核心重要性在于,将课本上抽象的“波的干涉”概念,变成了可以亲眼观察、亲手测量、亲自绘制的真实物理现象。通过这个过程,学生不仅能深刻理解驻波的形成原理(波的反射与叠加),更能掌握用实验验证理论、用数据描绘规律的科学基本方法,这是从理论学习迈向物理实证研究的关键一步。
*以上课题为部分参考,具体课程安排可能会调整
05.
有哪些大牛教授?
全部导师均由哥廷根大学各专业学科资深的科研人员带领,在各自领域内深耕数十年,且拥有丰富的教学经验
博士起步,丰富的授课经验
Dr. Birgit Drabent 教授
- 哥廷根大学化学系系主任
- 生物化学博士
- 化学&物理的国家州考考官
Dr. Maram Bader 教授
- 发育生物学和生物技术博士
- 植物体外培养与基因转殖方面从事博士后研究
- 自2008年担任XLAB讲师
Dr. Barbara Ritter 教授
- 哥廷根大学神经生理学博士
- XlAB神经生理学教授
Dr. Michael Ferber 博士
- 神经生理学博士
- 自2006年担任XLAB神经科学讲师
Dr. Christina Lumme 博士
- 生物物理学博士
- XlAB物理学讲师
*注:以上信息为参考师资,最终可能会根据课题方向调整
06.
学术之旅
项目时间:2026年7月19日-7月29日
课题方向:A班生物学方向;B班化学及物理方向
充实的日程安排
| 日期 | 日程 |
| DAY1 | 抵达法兰克福机场,乘车前往哥廷根
入住酒店,了解学习和生活环境 |
| DAY2 | 哥廷根大学教授欢迎致辞与项目介绍
A班:神经生理学:光传导 B 班:物理化学:纳米技术入门 |
| DAY3 | A 班:从基因到蛋白质
B 班:化学:阿司匹林合成 |
| DAY4 | A 班:从基因到蛋白质
B 班:化学:茶碱与咖啡因 |
| DAY5 | A 班:生物化学:生物膜
B 班:物理:放射性 |
| DAY6 | A 组:有机化学:微塑料
B 组:波动物理 |
| DAY7 | 哥廷根古镇周边游览 |
| DAY8 | 周边短途旅行与文化体验, 比如游览戈斯拉尔,参访历史性城市中心、早期矿坑以及 Rammelsberg博物馆( 联合国教科文组织世界文化遗产) |
| DAY9 | A 班:神经生理学:视觉系统
B 班:有机化学:微塑料 |
| DAY10 | A 班:生态学:湖泊生态系统
B 班:有机化学:聚合物合成与性质 |
| DAY11 | 乘机返回中国 |
*该日程供参考,可能会根据实际情况调整;每名学生仅可选择一个班级全程参与。
07.
往期高光时刻
听“老师学长说”还原真实科研
吴同学
这次实验让我掌握了神经电信号记录的核心技术,从电极植入到动作电位分析的全流程操作。通过研究蝗虫复眼对不同波长光的响应,我深刻理解了感光细胞如何将光信号转化为神经电信号,以及生物系统如何在能量效率与信息处理间取得平衡。实验过程中克服信号干扰的经历,培养了我解决实际问题的能力,也让我认识到严谨的实验设计对科研的重要性。
柯同学
XLAB 实验让我在物理、化学及环境科学方面获得了系统而深入的实践经验。我不仅掌握了如阿司匹林合成、咖啡因提取等有机合成实验,还亲自参与了双缝干涉、布拉格定律、X 射线光谱等物理实验,加深了对量子物理和材料结构的理解。同时,关于高分子与微塑料的研究让我意识到科学与环境问题的紧密联系。这些经历让我更加明确了自己对物理化学、材料科学等交叉领域的兴趣,并坚定了将来申请相关专业赴海外留学的决心与方向。
向右滑动查看更多感言
08.
费用说明
包含 :
- 德国期间全部课程费和参访费用
- 项目期间酒店住宿费用、酒店早餐、学校食堂午餐费用;晚餐自理
- 项目期间周末游览费用
- 项目期间带队老师服务费
- 国际保险费用
不包含 :
- 往返法兰克福国际机票
- 申根签证费与签证服务费
- 项目期间晚餐(需自理)
09.
开始申请
针对中国高中生仅开放36个名额!速度!
STEP1.你是否符合申请标准?
